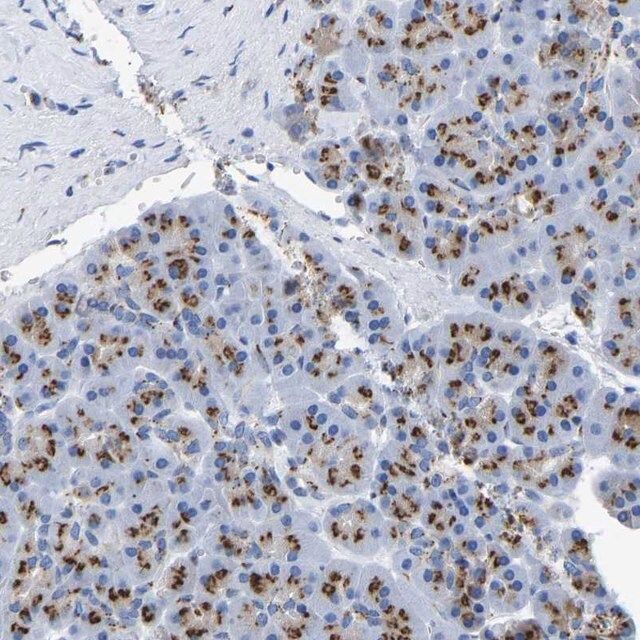

产品说明
一般描述
Transmembrane protein 87A (TMEM87A) is a multi-pass transmembrane protein belonging to the LU7TM family. Fluorescent tagging showed TMEM87A localization at the Golgi complex.
免疫原
Transmembrane protein 87A precursor recombinant protein epitope signature tag (PrEST)
应用
All Prestige Antibodies Powered by Atlas Antibodies are developed and validated by the Human Protein Atlas (HPA) project (www.proteinatlas.org)and as a result, are supported by the most extensive characterization in the industry.
The Human Protein Atlas project can be subdivided into three efforts: Human Tissue Atlas, Cancer Atlas, and Human Cell Atlas. The antibodies that have been generated in support of the Tissue and Cancer Atlas projects have been tested by immunohistochemistry against hundreds of normal and disease tissues and through the recent efforts of the Human Cell Atlas project, many have been characterized by immunofluorescence to map the human proteome not only at the tissue level but now at the subcellular level. These images and the collection of this vast data set can be viewed on the Human Protein Atlas (HPA) site by clicking on the Image Gallery link. To view these protocols and other useful information about Prestige Antibodies and the HPA, visit sigma.com/prestige.
生化/生理作用
Transmembrane protein 87A (TMEM87A) is involved in endosome-to-trans-Golgi network (TGN) retrograde transport. Golgi-associated retrograde protein complex is involved in endosome-to-TGN retrograde transport. It is composed of four subunits VPS51 (vacuolar protein sorting, VPS52, VPS53, and VPS54. Overexpression of TMEM87A in VPS54-knockout cells partially restores endosome-to-TGN retrograde and anterograde transport. TMEM87A is up-regulated in mammospheres of estrogen-receptor-positive breast cancer cells.
特点和优势
Prestige Antibodies® are highly characterized and extensively validated antibodies with the added benefit of all available characterization data for each target being accessible via the Human Protein Atlas portal linked just below the product name at the top of this page. The uniqueness and low cross-reactivity of the Prestige Antibodies® to other proteins are due to a thorough selection of antigen regions, affinity purification, and stringent selection. Prestige antigen controls are available for every corresponding Prestige Antibody and can be found in the linkage section.
Every Prestige Antibody is tested in the following ways:
- IHC tissue array of 44 normal human tissues and 20 of the most common cancer type tissues.
- Protein array of 364 human recombinant protein fragments.
联系
Corresponding Antigen APREST73258.
外形
Solution in phosphate-buffered saline, pH 7.2, containing 40% glycerol and 0.02% sodium azide
法律信息
Prestige Antibodies is a registered trademark of sigma-aldrich Co. LLC
基本信息
| 人类蛋白质图谱编号 | HPA018189 Human Protein Atlas characterization data |
产品性质
| 生物来源 | rabbit |
| 质量水平 | 100 |
| 偶联物 | unconjugated |
| 抗体形式 | affinity isolated antibody |
| antibody product type | primary antibodies |
| 克隆 | polyclonal |
| 产品线 | Prestige Antibodies® Powered by Atlas Antibodies |
| 形式 | buffered aqueous glycerol solution |
| species reactivity | human |
| 包装 | antibody small pack of 25 μL |
| 增强验证 | independent orthogonal RNAseq Learn more about Antibody Enhanced Validation |
| technique(s) | immunofluorescence: 0.25-2 μg/mL immunohistochemistry: 1:200-1:500 |
| 免疫原序列 | TTIFLKFDGEPCDLSLNITWYLKSADCYNEIYNFKAEEVELYLEKLKEKRGLSGKYQTSSKLFQNCSELFKTQTFSGDFMHRLPLLGEKQEAKENGTN |
| UniProt登记号 | Q8NBN3 |
| 运输 | wet ice |
| 储存温度 | −20℃ |
| Gene Information | human ... TMEM87A(25963) |
安全信息
| 储存分类代码 | 12 - Non Combustible Liquids |
| WGK | WGK 1 |
| 闪点(F) | Not applicable |
| 闪点(C) | Not applicable |
| 个人防护装备 | Eyeshields, Gloves, multi-purpose combination respirator cartridge (US) |